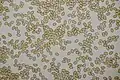
Sporen

Witte satijnvezelkop
| Witte satijnvezelkop | |||||||||||||||
|---|---|---|---|---|---|---|---|---|---|---|---|---|---|---|---|

| |||||||||||||||
| Taxonomische indeling | |||||||||||||||
| |||||||||||||||
| Soort | |||||||||||||||
| Inocybe geophylla (Pers.) P.Kumm. (1871) | |||||||||||||||

| |||||||||||||||
| lamellen | |||||||||||||||
| Synoniemen | |||||||||||||||
|
Inocybe geophylla var. geophylla | |||||||||||||||
| Afbeeldingen op | |||||||||||||||
| |||||||||||||||
De witte satijnvezelkop (Inocybe geophylla) is een giftige paddenstoel uit de familie Inocybaceae. Hij groeit vrijwel altijd in groepen op vochtige naald- of loofbosgronden. Hij is soms ook te vinden langs wegen, op de heide en in de duinen. De paddenstoel wordt in de zomer en in de herfst gevonden. De paddenstoel heeft een witte of lichtviolette kleur.
Kenmerken
Uiterlijke kenmerken
- Hoed
De hoed heeft een diameter van 1 tot 5 cm. Hij groeit eerst in een kegelvorm maar spreidt zich later uit en wordt dan bultig. De randen zijn vaak gespleten. Het oppervlak is wit of gebroken wit en vezelachtig zijdeachtig.
- Steel
De steel is 1 tot 6 centimeter hoog en 3 tot 6 millimeter dik. Het heeft dezelfde kleur als de hoed. De cortina laat geen ring achter.
- Lamellen
De lamellen zijn dicht opeengepakt en zitten vast aan de steel of bijna los en zijn crèmekleurig als ze jong zijn voordat ze donker worden tot een bruinachtige, gelijknamige aardekleur met de rijpende sporen. De randen zijn bolvormig en blijven witachtig
- Geur en smaak
De paddenstoel heeft een muffe geur. De vage geur is vergeleken met meel of vochtige aarde of zelfs beschreven als spermatisch. Het vlees smaakt scherp.
- Sporenprint
De sporenprint is okerbruin.
Microscopische kenmerken
De sporen zijn ellipsvormig tot amandelvormig, glad en meten ongeveer 7,5-10 × 4,5-6 µm. Er zijn talrijke kristaldragende (metuloïde), halflange gezwollen en aan het einde afgeknotte cystidia met een afmeting van 70 × 20 µm aanwezig.
Verspreiding
Inocybe geophylla komt algemeen voor en is wijdverbreid in Europa en Noord-Amerika. In het westen van Noord-Amerika wordt hij gevonden onder levende eik, den en douglasspar. In Nederland komt hij zeer algemeen voor. Hij staat niet op de rode lijst en is niet bedreigd.
Naam
De soortaanduiding geophylla is afgeleid van het Griekse woord geos dat "aarde" en het woord phyllon dat "blad" betekent. Dit verwijst mogelijk naar de groeiplaats tussen afgevallen blad.
Giftigheid
Deze paddenstoel bevat muscarine. De symptomen van muscarinevergiftiging zijn overmatige speekselvloed, transpiratie (zweten) en tranende ogen binnen 15 tot 30 minuten na inname. Bij hoge doses kunnen deze symptomen worden gevolgd door buikpijn, ernstige misselijkheid, diarree, wazig zien en kortademigheid. De vergiftigingssymptomen verdwijnen doorgaans binnen twee uur. Delirium komt niet voor. Het specifieke tegengif is atropine. Vanwege het tijdige begin van de symptomen is het ook raadzaam om braken op te wekken om schimmelmateriaal te verwijderen. Sterfgevallen als gevolg van consumptie van deze soort zijn niet gedocumenteerd.
Foto's
-
_P._Kumm_69630.jpg) Sporen
Sporen -
Sporen
Sporen -
 Cystidia
Cystidia -
 Cystidia
Cystidia